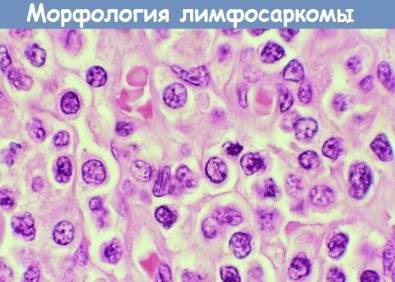

Содержание
Лимфосаркома одно из самых распространенных злокачественных заболеваний крови. Опухоли появляются группами по всей лимфатической системе, быстро прогрессируют, но их сложно обнаружить на начальных стадиях. Такая онкология встречается и у взрослых и у детей. Показатели смерти среди разных возрастных групп весьма высоки.
Лимфосаркома локализуется в лимфоузлах, миндалинах, вилочковой железе, селезенке, желудке, кишечнике, мочеточнике.
Раннее определение симптомов лимфосаркомы дает высокие шансы на благоприятный исход. В таких случаях лечение имеет положительный прогноз.
Классификация
Лимфосаркома относится к классу неходжинских лимфом. Болезнь также называют ретикулосаркомой, лимфобластомой.
Изначально опухоль возникает в отдельном узле или органе. Затем раковые клетки начинают курсировать с лимфой и кровью по всем частям организма и могут оседать в слабых местах. Формируется генеральный процесс со вторичными образованиями.
Явление сильно подрывает иммунитет, нарушает работы систем и органов.
- нодулярный – очаговый, фолликулоподобный (модульный). Легче поддается обнаружению и лечению, симптомы долгое время мягкие;
- диффузный – распространяется на множество органов и тканей. Протекает агрессивно, имеет значительно более низкий процент излечения.
Диффузная лимфосаркома в свою очередь классифицируется по признаку гистологии. Бластные типы приводят к ухудшениям максимально быстро, редко поддаются терапии, часто связаны с вирусами. Небластные протекают длительно, не столь мучительно, бывают в хронической доброкачественной форме.
| Бластные | Небластные |
|
|
Любой из этих типов может иметь крупноклеточную или мелкоклеточную структуру.
Лимфосаркома, как отмечают врачи, представляет собой злокачественное новообразование, возникающее из лимфатической ткани. Специалисты подчеркивают, что данное заболевание может проявляться в различных формах, включая агрессивные и менее агрессивные варианты. Важно отметить, что ранняя диагностика лимфосаркомы значительно увеличивает шансы на успешное лечение. Врачи рекомендуют обращать внимание на симптомы, такие как увеличение лимфатических узлов, необъяснимая потеря веса и ночные поты. Лечение может включать химиотерапию, радиотерапию и, в некоторых случаях, хирургическое вмешательство. Эксперты акцентируют внимание на необходимости регулярных медицинских осмотров, особенно для людей с предрасположенностью к онкологическим заболеваниям. Понимание природы лимфосаркомы и ее симптомов может сыграть ключевую роль в борьбе с этим заболеванием.

Стадии
Выделяют 4 стадии развития болезни:
- Локальная. Опухолью поражается один лимфоузел или одна группа таковых в изолированной области. Также сюда может относиться характерная опухоль в органе без затрагивания лимфатического узла;
- Регионарная. Поражение узлов или экстранодальных органов происходит на одной стороне диафрагмы в двух и более зонах;
- Генерализованная. Поражены несколько лимфатических узлов по двум сторонам диафрагмы, охвачена селезенка и, иногда орган вне лимфатической ткани;
- Диссеминированная. Поражение происходит по принципу диффузии. Опухоли распространяются множественно в лимфоидные ткани, узлы, органы, включая отдаленные (скелет, костный мозг).
Посмотрите видео на эту тему

При диагностировании дополнительно указывают категорию:
- А. Выраженных симптомов нет. Подтверждается только полным обследованием организма;
- В. Сопровождается сильной потливостью, активным снижением веса, постоянным повышением температуры тела.
1 и 2 стадии чаще всего протекают практически бессимптомно, имеют хорошие предпосылки к излечению.
3 и 4 степени почти всегда отмечаются классом В, нередко ведут к летальному исходу.
Локализация и симптомы

Раковые клетки при лимфосаркоме в большинстве случаев начинают распространение с грудной клетки, носоглотки и брюшной полости. Также опухоли могут появиться в лимфоузлах любой части тела. Костные, внутренние, мягкие ткани поражаются гораздо реже. В случае заражения головного мозга бывает сложно отличить от иных видов рака. Все виды имеют ряд сопутствующих симптомов.
Благодаря ним лимфосаркому можно заподозрить даже при схожести с более безобидным заболеванием.
| Локализация | Описание болезни |
| Средостение (грудная клетка) | Характерны отечность шеи, увеличение грудины, чувство распирания, давления между легкими и в вилочковой железе, посинение кожи снаружи, расширение вен на груди. Пациенты страдают затруднениями дыхания, отдышкой. Появляются осиплость голоса, приступообразный кашель с болевыми ощущениями и кровяными выделениями. Опухоль при пальпации заметна между ребрами, в яремной ямке.
Распространяется на сами легкие, перикард. Метастазы прорастают в надпочечники, почки, плевру и головной мозг. |
| Брюшная полость и забрюшинное пространство | В первую очередь страдает желудок, нередко путают с язвой или раком желудка. Тяжесть после еды, тошнота до рвоты, увеличение окружности живота в размерах, острая боль, отдающая в спину, кровотечения в ЖКТ. При переходе к кишечнику увеличиваются газы, нарушаются дефекация и мочеиспускание, возникает перитонит. Поражение редко выходит за пределы ЖКТ. |
| Носоглотка | Редко проявляет себя до поражения небных миндалин и горловых лимфоузлов. Трудности с глотанием, слухом, дыханием, синюшный цвет покровов, боль в горле сначала похожи на простуду. Со временем отекает язык, повышается отделение слюны, нарушается речь, появляется ощущение инородного тела у корня языка, тембр грубеет. Миндалины становятся бугристые. |
| Лимфоузлы периферии | Сильнее всего отекают лимфоузлы над ключицами. Характерны выраженные припухлости, боли и подвижность узлов при пальпации. При прогрессировании в аналогичное состояние приходят все лимфоузлы организма. Ощущение общей слабости. Разрастается в костный мозг и селезенку. |
При поражении лимфосаркомой селезенка увеличивается, в левом боку наблюдаются тяжесть, боли, температура регулярно поднимается до 38-39С.
Распространение в мозг сложно отличить от других видов опухолей. В больших полушариях повышается давление, случаются параличи и парез. Замечено частое сочетание лимфосаркомы мозга с ВИЧ-инфицированием.
Симптомы опухоли щитовидной железы аналогичны носоглотке, со сдвигом давящих ощущений вглубь гортани.
Лимфосаркома кости встречается гораздо реже. Ее отличают постоянные боли в костях, их повышенная ломкость, нарушения подвижности суставов. В районе позвоночника заметны опухлости, сдавливается спинной мозг, что ведет к нервным расстройствам.
Главный признак лимфосаркомы крови – геморрагический диатез с анемией.
Лимфосаркома — это злокачественное новообразование, возникающее из лимфатической ткани. Многие люди, столкнувшиеся с этой болезнью, отмечают, что важным аспектом является ранняя диагностика. Симптомы могут быть неочевидными: увеличение лимфатических узлов, усталость, ночные поты и потеря веса. Обсуждая лечение, пациенты часто упоминают о важности мультидисциплинарного подхода, который включает химиотерапию, радиотерапию и, в некоторых случаях, трансплантацию стволовых клеток. Поддержка близких и психологическая помощь также играют ключевую роль в процессе борьбы с болезнью. Многие делятся своим опытом, подчеркивая, что информация о лимфосаркоме и доступ к квалифицированной медицинской помощи могут существенно повлиять на исход лечения.

Причины возникновения

- радиационное воздействие. Ионизирующее облучение часто приводит к лимфосаркоме, лейкозу, раку щитовидки. Даже радиотерапия от иной онкологии способна привести к лимфосаркоме, как к побочному эффекту;
- отравление токсическими веществами. Бензол, инсектициды, гербициды в больших количествах способны вызывать данное заболевание;
- иммунодефицит. Наблюдается при наличии ВИЧ, перенесенной пересадки органов, как результат длительной медикаментозной терапии;
- бактерия Хеликобактер пилори (Helicobacter pylori). При длительном наличии вызывает не только язвы, но и различные опухоли;
- вирус Эпштейна-Барр. Особенно часто приводит к лимфосаркоме у больных СПИДом и хромосомными аномалиями.
Факторы риска, распространенность заболевания
Главным фактором риска являются генетические предрасположенности. Высок риск заболевания у людей, в чьих семьях лимфосаркома уже имела место быть, особенно неоднократно. Врожденные нарушения иммунитета делают организм чувствительным не только к инфекциям, но и к опухолевой активности на протяжении всей жизни.
Лимфосаркома у детей особенно распространена при наличии синдрома Дауна (часто проявляется в 4-5 лет). Риск заболевания ежегодно возрастает у всех после 40 лет (пик приходится на 60 лет). Лимфосаркоме средостения больше подвержены женщины до 35. В остальных случаях больными чаще являются мужчины.
В группу риска входят страдающие ожирением.
Нарушенный обмен веществ значительно снижает сопротивляемость организма раковым провокаторам.
Метастазы при лимфосаркоме
Распространение метастазов при лимфосаркоме происходит с током лимфы (лимфогенно) и крови (гематогенно). Рост очагов поражения по лимфе называется генерализацией. Этот процесс начинается уже с начальными стадиями заболевания.
Сначала метастазы проникают в региональные, а затем и отдаленные лимфоузлы. Далее заражение переходит к селезенке, легким, миндалинам, в костный мозг, печень. Кожа и мягкие ткани страдают в последнюю очередь. При достижении отдаленных органов раковые клетки активно взаимодействуют с кровью.
Происходит лейкимизация с последующим острым лимфобластным лейкозом.
Диагностика

Диагностические мероприятия включают в себя:
- анализы крови и мочи. Общеклинические и биохимические на сыворотке. Гемоглобин умеренно снижается. Эритроциты находятся значительно ниже нормального показателя.СОЭ, ретикулоциты, лимфоциты заметно повышены. Лейкоциты – немного выше обычного уровня. Проводятся тесты на онкомаркеры ЛДГ, микроглобулин, фосфатазу. Отмечается наличие бластных клеток;
- анализы на ВИЧ, сифилис. Выявляется подверженность заболеваниям иммунитета, факторы риска;
- УЗИ. С помощью ультразвука изучается состояние селезенки, печени, узлов периферии. Без данной диагностики особенно сложно выявить лимфобластомы паховые и лимфосаркому в брюшной полости;
- рентген. Необходим для оценки состояния лимфоузлов средостения, показывает наличие жидкости в плевре;
- КТ. Томография компьютерной техникой актуальна при обследовании шеи, головы, брюшины, полостных участков с опухолями. Помогает увидеть состояние органов, тканей вокруг зоны поражения;
- МРТ. Магнитно-резонансную томографию подключают при подозрении на лимфосаркому с проникновением в головной и спинной мозг;
- радиоизотопное сканирование скелета. Позволяет определить саркому на костях скелета;
- биопсия. Берется из пораженной ткани, чтобы определить злокачественный или доброкачественный характер. Забор материала осуществляется иглой или скальпелем при операции;
- пункция люмбальная. Демонстрирует состояние нервной системы за счет выявления раковых клеток в ликворе;
- миелограмма. Оценка костного мозга на наличие метастазов, поскольку именно в данные ткани процесс распространяется с самой большой скоростью. Сочетается с биопсией и пункцией;
- цитология и гистология. Еще один способ изучения пораженной ткани на характер опухоли, прогноз излечения. Проводится после биопсии на основе взятого материала. Часто служит окончательной основной для выбора тактики лечения;
- другие методы. Для получения полной картины об организме дополнительно могут быть назначены кардиологическая, иммуногистохимическая диагностики, эндоскопия кишки и желудка. При подозрении на рак кожи осуществляют соскоб с поверхности тела.
Совокупность данных мероприятий помогает определить характер заболевания, составить прогноз на излечение, выбрать терапию.
Лечение
Лечение лимфосаркомы выбирается по стадии, уровню метастазирования, возрасту и общему анамнезу пациента. Как правило, сочетают терапию медикаментами и физическим воздействием на опухоль.
Препараты
Медикаменты – основное средство лечения лимфосаркомы.
Используются лекарства, которые угнетают воспалительные процессы, тормозят деление и рост зараженной ткани, способствуют уменьшению опухоли.
Все препараты делятся на группы:
Химиотерапевтические
Преднизолон. Кортикостероид. Таблетки, растворы, мази. Подавляет активность опухолевых клеток, снижает воспаление, отек. Уменьшает число антител в крови. Имеет иммунодепрессивное, противоаллергическое, антиэкссудативное действие. Противопоказания:
- Повышенная чувствительность;
- патологическая кровоточивость;
- инфекции суставов, кожи, глаз.
Применение у детей, беременных, пациентов с почечной и печеночной недостаточностью оправдано только при превышении пользы для жизни.
Таблетки – 90-130 рублей; ампулы – 20-60 рублей; мазь – 20-50 рублей.
Дексаметазон. Глюкокортикоид синтетического происхождения на основе гормонов надпочечников. Регулирует белково-углеводный обмен в тканях, снижает отечность, уменьшает размер опухоли, блокирует воспаление, позволяет избегать сильных аллергий на другие лекарства. Противопоказания:
- Язвенные и острые заболевания ЖКТ;
- иммунодефицит;
- инфекции, паразитарные заражения;
- эндокринные патологии;
- сердечная, почечная, печеночная недостаточность;
- глаукома;
- острые психозы и остеопорозы.
Таблетки — от 40 рублей; Ампулы – 70 рублей.
Блеомицин. Противоопухолевый антибиотик. Подавляет метастазы, способствует предотвращению увеличения опухоли. Может применяться при лучевом лечении. Противопоказания:
- Выраженные нарушения дыхательной функции;
- почечная, сердечно-сосудистая недостаточность;
- беременность;
- фиброз легких.
1200-1400 рублей за ампулу.
Цитостатики
Адриамицин. Антрациклиновый антибиотик. Нарушает матрицу и ДНК опухоли, способствует ее активному разрушению. При длительном применении может иметь обратный эффект из-за высокой канцерогенности. Противопоказания:
- Анемия;
- гепатит;
- тромбовые и острые заболевания сердца и сосудов;
- беременность;
- предварительное лечение большой дозой других антрациклинов и антраценов.
От 200 рублей за 1 ампулу.
Флударабин. Противоопухолевый цитостатик, Видоизмененный видарабин с добавлением вторированного нуклеотида. Нарушает синтез ДНК опухоли, тормозит ее рост. Противопоказания:
- Беременность и лактация;
- анемия;
- гиперчувствительность.
С осторожностью при наличии инфекций, грибков в организме и при иммунодефиците. От 1500 рублей за флакон.
Онкавин. Алкалоид на основе винкристина. Раствор для в/в инъекций. Оказывает противоопухолевое действие. В составе растительный экстракт розового барвинка. Блокирует метафазы, подавляет синтез излишнего белка. Противопоказания:
- Острые инфекционные, бактериологические, вирусные заболевания;
- индивидуальная непереносимость;
- беременность и лактация;
- недостаточность костномозгового кроветворения, печени, почек;
- желтуха;
- гиперурикимия;
- предшествующая лазерная терапия;
- нейродистрофия.
160-250 рублей.
Винкристин. Алкалоид на основе винкристина сульфата, гидроксида натрия, серной кислоты и маннитола. Предотвращает метостазирование, разрушает ДНК опухоли. Используется в виде инъекций.
- Одновременная лучевая терапия;
- печеночные патологии;
- беременность, лактация;
- гиперчувствительность;
- нейромышечные болезни;
- непроходимость кишечника;
- обостренные инфекции.
Нежелателен в пожилом возрасте. 80-220 рублей.
Лейковорин. Порошок или таблетки, активирующие выработку фолиевой кислоты. Является антидотом, блокирует деление раковых клеток.
- Анемия с острым дефицитом витамина В12;
- индивидуальная аллергия;
- эпилепсия.
С осторожностью при алкоголизме, детям.
От 350 рублей за все формы выпуска.
Цитозар. Антиметаболит. Тормозит деление раковых ДНК. Углеводная часть содержит арабинозу.
- Беременность и кормление грудью;
- непереносимость;
- острые болезни печени, почек, сердца.
От 500 рублей за флакон.
Циклофосфан. Входит в группу оксазафосфоринов. Надежно разрывает связи между нитями ДНК опухоли, замедляет переход к фазе метастазирования. Быстро выводится из организма почками.
- Чувствительность к компонентам;
- цистит;
- сильные поражения костного мозга;
- плохая работа почек;
- инфекции в активной стадии.
От 90 рублей за ампулу.
Циклофосфамид. Противоопухолевая активность препарата проявляется на биологическом уровне. Ферменты лекарства органично внедряются в клетки и блокируют рост опухоли.
- Аллергия на препарат;
- почечные болезни;
- гипоплазия костного мозга;
- анемия, склонность к тромбам;
- терминальная стадия онкологии;
- лактация, беременность.
50-60 рублей.
Метотриксат. Аниметаболит. Разрушает ДНК, препятствует дальнейшему синтезу, репарации опухолевых тканей. Особенно эффективен при поражении полости рта, костного мозга, кишечника и мочеточника.
- Высокая чувствительность к компонентам;
- беременность и кормление грудью;
- недостаточность почек, печени;
- анемия, тромбы, нейтропения и лейкопения.
От 150 рублей за ампулы.
Доксарубицин. Антибактериальное, противоопухолевое средство. Основан на антрациклиновых грибках. Подавляет опухолевые ДНК, напрямую воздействуя на стенки клеток. Имеет прямое антитоксическое действие.
- Сверхчувствительность к антрациклинам;
- тяжелые аритмии, недостаточности почек и печени, вирусы;
- инфаркт миокарда;
- опухоли мочевого пузыря и цистит.
От 200 рублей.
Прочие
Интерферон. Противовирусное, иммуномодулирующее. Формирует клеточный иммунитет, повышает сопротивляемость вторичному развитию опухолевого процесса.
- Тяжелые психические и нервные расстройства;
- острые болезни почек;
- эпилепсия.
Ампулы от 110 рублей.

Зевалин. Консолидирующая терапия после основного лечения. Препятствует рецидивам.
- Беременность и лактация;
- чувствительность к ритуксимабу, белку мыши, ибритумомаба тиуксетану, иттрия хлориду;
- возраст до 18 лет.
Около 14 тысяч евро курс.
Курсы проводятся внутривенно и перорально. На 1-2 стадиях стандартно назначается 3 круга по 5 дней с месячным перерывом. На 3-4 стадиях необходимо уже 6-17 повторов выбранной химиотерапии. Контроль осуществляется по состоянию пациента, анализам крови. Постоянное наблюдение позволяет оценивать прогресс, отменять или заменять неподходящие цитостатики.
В случаях успеха после отмены химии прописывают двухгодичный прием Интерферона и Ритуксимаба для стимуляции ослабленного иммунитета.
Схемы лечения препаратами
Монохимиотерапия требует больше времени для достижения результата, бывает малопродуктивна. Сочетание нескольких наименований в полихимиотерапию повышает шанс стойкой ремиссии на 10-20%, к тому же позволяет подключить препараты 2 и 3 поколений. Максимальный результат дают следующие высокодозные схемы:
| CHOP | Циклофосфамид+Адриамицин+Онковин+Преднизолон |
| COP | Циклофосфамид+Онковин+Преднизолон |
| BACOP | Блеомицин+Адриамицин+Циклофосфамид+Онковин+Преднизолон |
| mBACOD | Метотрексат+Блеомицин+Онковин+Циклофосфамид+Адриамицин+Дексаметазон |
| COMLA | Циклофосфан+Винкристин+Метотрексат+Лейковорин+Цитозар |
Для 1 стадии практикуется 2-3 цикла CHOP или COP.
От 2 стадии схема выбирается индивидуально, возможно их чередование, количество курсов повышается до 6-8. Перерывы составляют от 1 до 3 недель.
При некоторых видах сарком для завершения лечения необходимо подключение Зевалина, который блокируют специфические антитела в клетках лимфомы.
Лучевая терапия

Лучи воздействуют на новообразование, чем замедляют его рост. На 1 и 2 стадии успех такого сочетания достигает 40%, удается избежать активного метастазирования, уменьшить болевые синдромы. На 3-4 стадиях облучение используется крайне редко, если есть необходимость обработки всех лимфоузлов, костей, головного мозга и польза превышает риски.
Стандартно курс составляет 30 дней по 2-2,5 Гр на очаг (40-45 Гр суммарно).
Ситуационное лечение
Лимфомы часто сопровождаются анемией, тромбоцитопенией. В таких случаях к схеме параллельно добавляют переливания эритроцитарных масс или тромбоконцентратов.
В некоторых случаях иммуномодулирование интерфероном необходимо в процессе курсов, а не после них. При заражении вирусами обязательно подключаются антибиотики.
Химиотерапия имеет много побочных эффектов. Смягчить приступы тошноты, желудочных расстройств, улучшить самочувствие помогает соблюдение диеты с минимумом жирных продуктов животного происхождения, сахара, белой муки. Основой рациона становятся железосодержащие продукты, диетическое мясо, овощи и фрукты.
Полезны гречка, фасоль, зеленые яблоки, индейка.
Оперативное вмешательство, трансплантация
Операции применяют в случаях опухолей желудка, костей, молочных, щитовидных желез, яичников и яичек. Цель такого вмешательства – отсечь как можно больше раковых клеток для спасения функциональности органа и препятствия метастазирования.
Нередко проводится трансплантация костного мозга через несколько месяцев после химиотерапии. Такой подход позволяет быстрее восстановить показатели крови после цитостатиков.
Материал для пересадки берут у самого пациента до начала курса медикаментов. Если онкология задела костный мозг, используют донорские стволовые клетки.
Чужеродный материал несет больше риска для отторжения, поэтому такого подхода стараются избегать.
Другие методы лечения
Существуют народные рекомендации по лечению лимфосаркомы. Для восстановления лимфы рекомендуется пить отвары шиповника, льна, овса, сосновых побегов и чистотела. Без врачебной консультации такой подход может привести к плачевным последствиям. Самолечение строго не рекомендуется!
Клиники

- СМ-Клиника. Санкт-Петербург. Отделение онкологии хорошо оснащено, специалисты имеют большой опыт работы с подобными опухолями;
- Экстрамед. Москва. Современные методы лечения и последующей реабилитации. Созданы условия для комфортного стационара;
- Хадасса. Израиль. Крупный медицинский центр с достойным онкологическим отделением. Лечит все виды рака, предлагает разные формы стационара;
- РНПЦ онкологии и медицинской радиологии. Минская область, агрогородок Лесной-2. Терапия всех видов раковых болезней по направлениям химии, облучения, хирургии;
- Бад Триссль. Обераудорф. Немецкая онкологическая клиника, специализирующаяся на опухолях внутренних органов, лучевой терапии. Расположена в окружении альпийских гор, что уменьшает стресс и укрепляет иммунитет.
Каждая клиника имеет собственный прейскурант.
Совокупные траты определяются выбранным лечением, формой стационара, длительностью курсов. В среднем при дневном посещении один курс обходится в 40-60 тысяч рублей.
Инвалидность

В 1 группу относят пациентов с тяжелой стадией, когда ему постоянно требуется уход и возможность работать отсутствует.
2 группа включает онкобольных со значительными нарушениями организма, но не требующих постоянного ухода. Разрешена работа в специальных условиях.
К 3 группе относят тех, кто вынужден перейти к сокращению трудовой недели, понижению квалификации. Чаще это пациенты с начальными обратимыми стадиями.
Решение выносит комиссия на основании многих факторов.
Однозначного ответа по вопросам инвалидности при лимфосаркоме дать нельзя.
Прогнозы
Огромную роль в прогнозировании исхода лимфосаркомы имеют факторы возраста, стадии, очага опухоли.
Для 1-2 стадий излечимость доходит до 90%, выживаемость часто превышает 5 лет. В половине случаев удается достичь долговременной ремиссии.
Генерализованные процессы 3-4 стадий редко поддаются полному излечению. Рубеж продолжительности жизни в 5 лет проходят не более 20% пациентов. Около 3 лет проживает до 50% больных. Долгие ремиссии затруднительны, но известны случаи таковых даже до 8 лет.
Качество жизни при полном избавлении от лимфосаркомы восстанавливается до уровня здорового человека.
Профилактика
Профилактические меры заболевания не разработаны и не выявлены. Механизм активации раковых клеток до конца не изучен. Рекомендации медиков весьма скромны:
- вести здоровый образ жизни с минимумом вредных привычек,
- внимательно относится к сигналам своего организма,
- регулярно обследоваться,
- избегать агрессивных химических и радиационных воздействий.
Лимфосаркома опасна как любое онкологическое заболевание.
Половина успеха в борьбе с ней – своевременное обнаружение и начало терапии.
Вопрос-ответ
Что такое лимфосаркома и как она развивается?
Лимфосаркома — это злокачественная опухоль, возникающая из лимфатической ткани. Она может развиваться в различных частях тела, включая лимфатические узлы, селезенку и костный мозг. Основные факторы, способствующие развитию лимфосаркомы, включают генетическую предрасположенность, вирусные инфекции (например, вирус Эпштейна-Барра) и ослабленный иммунитет.
Каковы основные симптомы лимфосаркомы?
Симптомы лимфосаркомы могут варьироваться в зависимости от стадии заболевания и его локализации. Наиболее распространенные симптомы включают увеличение лимфатических узлов, необъяснимую потерю веса, ночные поты, лихорадку и усталость. Важно обратиться к врачу при появлении этих симптомов для своевременной диагностики.
Какие методы лечения применяются при лимфосаркоме?
Лечение лимфосаркомы зависит от стадии заболевания и общего состояния пациента. Основные методы включают химиотерапию, радиотерапию и, в некоторых случаях, хирургическое вмешательство. Важно, чтобы лечение проводилось под контролем опытного онколога, который сможет подобрать наиболее эффективную терапию для конкретного пациента.
Советы
СОВЕТ №1
Обязательно проконсультируйтесь с онкологом при первых симптомах, таких как увеличение лимфатических узлов, необъяснимая потеря веса или постоянная усталость. Ранняя диагностика лимфосаркомы может значительно повысить шансы на успешное лечение.
СОВЕТ №2
Изучите доступные методы лечения, включая химиотерапию, радиотерапию и иммунотерапию. Понимание различных подходов поможет вам и вашим близким принимать обоснованные решения о лечении.
СОВЕТ №3
Поддерживайте здоровый образ жизни, включая сбалансированное питание и регулярные физические нагрузки. Это поможет укрепить иммунную систему и улучшить общее состояние здоровья во время лечения.
СОВЕТ №4
Не стесняйтесь обращаться за поддержкой к психологам или группам поддержки. Эмоциональное здоровье так же важно, как и физическое, и общение с людьми, которые понимают вашу ситуацию, может оказать значительное положительное влияние.
















